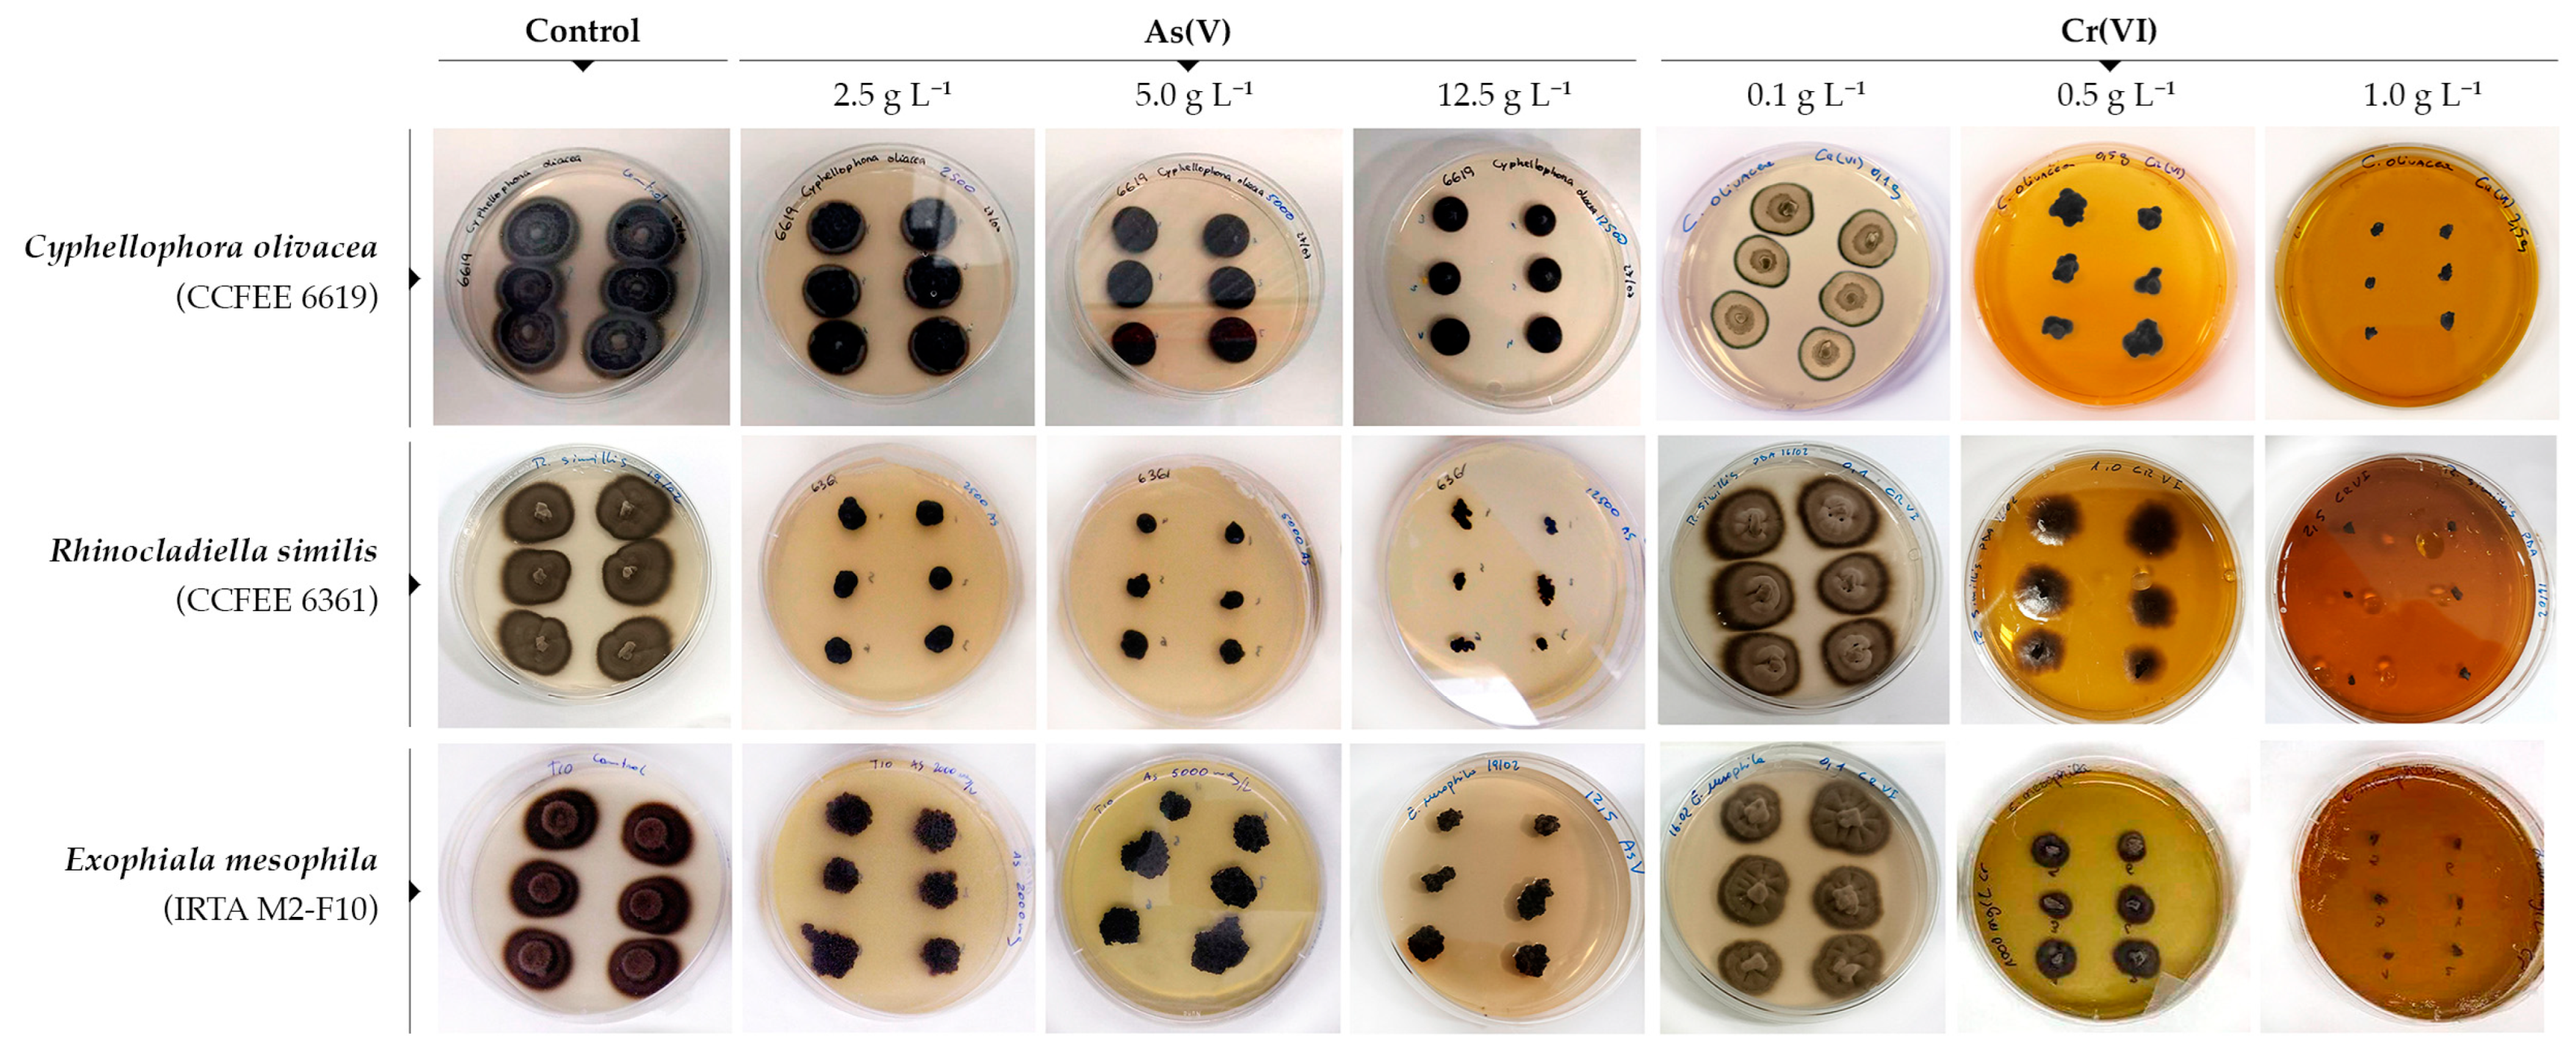
Jof 10 00047 g002 Jof 10 00047 g002

Abstract
A collection of 34 melanized fungi isolated previously from anthropogenic contaminated sites were assessed for their tolerance to toxic concentrations of As(V) and Cr(VI) anions. Three strains of the species Cyphellophora olivacea, Rhinocladiella similis, and Exophiala mesophila (Chaetothyriales) were identified as hyper-metallotolerant, with estimated IC50 values that ranged from 11.2 to 16.9 g L−1 for As(V) and from 2.0 to 3.4 g L−1 for Cr(VI). E. mesophila and R. similis were selected for subsequent assays on their biosorption capacity and kinetics under different pH values (4.0 and 6.5) and types of biomass (active and dead cells and melanin extracts). The fungal biosorption of As(V) was relatively ineffective, but significant removal of Cr(VI) was observed from liquid cultures. The Langmuir model with second-order kinetics showed maximum sorption capacities of 39.81 mg Cr6+ g−1 for R. similis and 95.26 mg Cr6+ g−1 for E. mesophila on a dry matter basis, respectively, while the kinetic constant for these two fungi was 1.32 × 10−6 and 1.39 × 10−7 g (mg Cr6+ min)−1. Similar experiments with melanin extracts of E. mesophila showed maximum sorption capacities of 544.84 mg Cr6+ g−1 and a kinetic constant of 1.67 × 10−6 g (mg Cr6+ min)−1. These results were compared to bibliographic data, suggesting that metallotolerance in black fungi might be the result of an outer cell-wall barrier to reduce the diffusion of toxic metals into the cytoplasm, as well as the inner cell wall biosorption of leaked metals by melanin.
1. Introduction
Heavy metals and metalloids (HMMs) are found naturally in the Earth’s crust at relatively diffused amounts, but they might become concentrated as a result of anthropogenic activities such as mining, agriculture, and husbandry, as well as several industrial manufacturing processes. Because of their inherent high toxicity, pollution with HMMs has become a pressing public health issue in many parts of the world [1]. Metal ions persist in the environment due to the bioaccumulation tendency of living organisms and their limited capacity to metabolize them into less toxic forms [2]. Once absorbed into the cell, HMMs bind to vital components, such as structural proteins, enzymes, and nucleic acids, impairing several fundamental metabolic functions [3].
Groundwater contaminated with arsenic is still poisoning millions of people, primarily from developing countries, and has been listed by the WHO as one of the ten chemicals of major public health concern [4,5]. Arsenic exposure to humans can be attributed to various sources, including natural deposits, agricultural pesticides, and industrial effluents [5]. Natural geochemical processes can also lead to toxic and subtoxic concentrations of arsenic in groundwater [6]. Arsenic-contaminated water typically contains both arsenate and arsenite species, As(V) and As(III). Water pollution with chromium is gaining more consideration because it is globally widespread and also represents an important public health concern [7,8]. The majority of chromium released into the environment originates from industrial activities, particularly from the processing and manufacturing of chemicals, minerals, steel, leather tanning, textile dyeing, metallurgical operations, and various other industrial processes [7]. The most stable oxidation states of chromium in water correspond to the hexavalent Cr(VI) and trivalent Cr(III) species, but concerns are primarily related to Cr(VI) owing to its high biotoxicity.
A number of technical approaches for the remediation of HMM pollution and water purification have been proposed [9]. These solutions should rely on technically and economically viable methods, such as the biosorption of HMMs into readily available biomass sources. Many reports in the literature describe the capacity of pure cultures of bacteria [10,11], algae [12], aquatic plants [13], and fungi [14,15] to remove HMM ions from aqueous solutions. Such bioremediation alternatives are an interesting option for the decontamination of water and soil because these processes require few reagents and energy, they generate relatively low amounts of toxic waste products, and because biosorption is highly effective in reducing HMMs at relatively low concentrations [1,13]. However, the biotechnological removal of HMMs still faces some scalability problems associated with the difficulty to find suitable microorganisms that are able to cope with a highly oligotrophic and toxic environment while having a high HMM biosorption potential.
In this context, one particular group of ascomycetes known as black fungi (BF), because of their common polymorphism as yeast-like, hyphal, and meristematic growth, have been identified recently for their capacity to bind heavy metals to their cell wall [16,17]. These fungi are characterized by a high morphological and metabolic plasticity and poly-extremotolerant traits, which allow them to colonize a diverse range of often divergent and uncommon habitats [18]. The main defining character of BF is a strongly melanized cell wall, which confers them protection against extreme environmental conditions, such as exposure to UV and ionizing radiation, desiccation, cold/hot temperatures, high salinity, and oligotrophic environments [19,20]. This latter trait has also been linked to the ability to use toxic volatile hydrocarbons as the only source of carbon and energy [21,22]. As for their identities, BF primarily fall into two main phylogenetic groups: the Eurotiomycetes (Chaetothyriales) and the Dothideomycetes (Dothideales, Cladosporiales, and a few other related orders in the Mycophaerellales) [18,23].
The structure of fungal melanin is somewhat similar to soil humic acids with respect to volatile compounds released upon pyrolysis and amino acid hydrolysis [24]. In particular, the melanin of BF is composed of short-distance non-hydrolysable strong carbon–carbon bonds based on 1,8-dihydroxynaphthalene (DHN), modified with different functional groups, such as carboxyl, phenolic, hydroxyl, and amino [25,26], which provide many potential binding or biosorption sites for metal ions [27]. Special attention has been given to two main functions attributed to melanin in relation to metal ions: as a reservoir for the temporary storage and release of certain nutrients, and as chelating agents of HMMs for protecting the cell against metal toxicity. However, the biodiversity of metallotolerant BF and their HMM biosorption potential have seldom been investigated.
In this study, we screened a collection of BF species isolated previously from diverse anthropogenic-polluted sites for their tolerance to As(V) and Cr(VI), selected, respectively, as a model heavy metal and metalloid. The biosorption potential was determined on selected metallotolerant strains, using living fungal cultures, dead biomass, and melanin extracts. The obtained results could give new insights into the biology of BF and might contribute to the development of biotechnological applications.
2. Materials and Methods
2.1. Biological Material
A culture collection of 34 BF strains confidently identified at the species level were used (Table 1). Most of these strains were isolated during previous studies [21,28,29] from car fuel dispensers and tanks, stone buildings exposed to pollution and toxic biocides, and washing machines. These strains are currently maintained at the Culture Collection of Fungi from Extreme Environments (CCFEE) at the Tuscia University in Viterbo, the Westerdijk Fungal Biodiversity Center (formerly Centralbureau voor Schimmelcultures—CBS), and the Institute of Agrifood Science and Technology (IRTA).
Table 1.
List of melanized fungal strains used in this study.
2.2. Metallotolerance Assays
The capacity of the collected fungal strains to grow in the presence of increasing concentrations of As(V) and Cr(VI) was evaluated on solid cultures. Into Petri dishes (12 cm in diameter), we poured potato dextrose agar (PDA; Condalab, Torrejón de Ardoz, Spain) supplemented with 2.5, 5.0, 7.5, 10.0, or 12.5 g of As5+ L−1 from sodium arsenate (Na2HAsO4·7H2O; Thermo Fisher Scientific, Kandel, Germany) and 0.1, 0.5, 1.0, 1.5, and 2.5 g of Cr6+ L−1 from potassium dichromate (K2Cr2O7; Scharlab ExpertQ®, Sentmenat, Spain). Each BF strain was inoculated six times with an inoculation loop on each agar plate containing a defined concentration of As(V) or Cr(VI). The radial growth of each fungal colony was measured by averaging orthogonal diameters, and this value was then averaged again for all six colonies from every single plate. These measurements were repeated after 7, 15, 30, 45, and 60 days of incubation, which was performed at 25 °C under dark conditions. This prolonged timeframe was established to account for the potential long-term adaptation of slow-growing BF strains. Unamended control plates were also included. The tolerance index (TI) was calculated for every strain by dividing the measured growth when exposed to the metal in relation to the control plates.
2.3. Production of Fungal Biomass
Fungal biomass for biosorption experiments on selected BF strains was produced in 0.5 L batch liquid cultures incubated at room temperature under shaking conditions (80 rpm) for 10 days. Yeast extract (4 g L−1) was supplied as the carbon and energy source, and macronutrients were added in the form of 4.5 g of KH2PO4, 0.5 g of K2HPO4, 2.0 g of NH4Cl, and 0.1 mg of MgSO4·7H2O per liter. Mineral micronutrients were added in the form of 2 mL of a stock solution that contained 120 mg of FeCl3, 50 mg of H3BO3, 10 mg of CuSO4·5H2O, 10 mg of KI, 45 mg of MnSO4·H2O, 20 mg of Na2MoO4·H2O, 75 mg of ZnSO4·H2O, 50 mg of CoCl2·6H2O, 20 mg of AlK(SO4)2·12H2O, 13.25 g of CaCl2·H2O, and 10 g of NaCl per liter. Spore suspensions of pure cultures (0.5 mL, >106 CFU mL−1) were used as inoculant. After 10 days of incubation, the fungal biomass was harvested by centrifugation (20 min at 4000 rpm) and washed with milliQ sterilized water. This process was repeated three times before using fungal biomass in batch biosorption assays.
2.4. Extraction and Purification of Melanin
Melanin was extracted from pre-grown BF cultures by adapting an acid hydrolysis method used previously with other fungi [30,31]. Briefly, harvested fungal biomass was homogenized in 100 mL of 1 M NaOH (120 rpm for 10 min) and treated with hot alkali (1 M NaOH at 121 °C for 20 min). The resulting suspension was centrifuged at 10,000 rpm for 10 min to remove fungal biomass, and the brownish liquid fraction was acidified to pH 2.5 with HCl 6 N and incubated for 12 h at 100 °C. The resulting black precipitate was centrifuged (4000 rpm for 20 min) and washed with deionized water three times. The precipitate was then lyophilized at a pressure of 0.7 mBar at −50 °C for 24 h, and the obtained melanin powder was kept at −20 °C until use.
2.5. Biosorption Assays
The capacity of the fungal biomass to accumulate As(V) and Cr(VI) ions was tested on a oligotrophic liquid medium to minimize growth. Consequently, the number of sorption sites remained consistent. This medium contained a buffer of 35 mM K2HPO4/NaH2PO4·2H2O (pH 6.5), glucose (0.3%), and yeast extract (0.01%), along with 20 to 200 mg L−1 of As(V) or Cr(VI), added as Na2HAsO4·7H2O or K2Cr2O7, respectively. Biomass from living and heat-inactivated fungal cultures (on a dry matter basis, approx. 50 mg DM) was resuspended into the liquid mineral medium and incubated in serum flasks (30 mL) under sterile conditions on a shaker (80 rpm at 25 °C). Experiments were carried out in triplicate, and liquid samples were taken after 2, 5, 7, 14, 21, and 30 days of incubation to measure the concentration of As(V) and Cr(VI). Biosorption experiments were repeated at pH 4.0 by adding 0.1 M HCl.
The assays for the biosorption of Cr(VI) onto melanin extracts were performed with 0.3 g of melanin powder resuspended in 50 mL of a solution (pH 6.5; 150 rpm; 25 °C). The initial solution’s Cr(VI) concentration was 30 mg Cr6+ L−1 and incubations lasted up to 72 h. Incubations were carried out in triplicate, and liquid samples were taken regularly to measure the time-course evolution of the concentration of Cr(VI).
2.6. Analytical Methods
The content of total arsenic in liquid culture supernatant was determined using Flame Atomic Absorption Spectroscopy (Model SpectrAA-110, Varian, Mulgrave, Australia). Chromium (VI) in the liquid fraction was determined with a colorimetric method based on the reaction with the complexing agent 1,5-diphenylcabazide (Sigma-Aldrich, St. Louis, MI, USA) that forms a purple-violet-colored complex, which was quantified by measuring the absorbance at a wavelength of 540 nm using a spectrophotometer (model EMC-11S UV brand, Duisburg, Germany).
2.7. Numerical Methods and Statistical Analysis
The software GraphPad Prism version 8.0 (GraphPad Software, San Diego, CA, USA) was used for performing one-way ANOVA (multiple comparisons Tukey test) and for the calculation of the metal concentration causing a 50% inhibition of fungal growth (IC50). After a given time of incubation, IC50 was calculated by fitting the tolerance index (TI) measurements at different HMM concentrations (Ct) to a two-parameter Hill logistic model (IC50 and slope factor h; Equation (1)).
As for the biosorption assays, the specific amount of the HMMs that is taken up at any given time (qt) by a defined amount of fungal biomass Ma, when incubated at an initial concentration C0 in batch incubations of liquid volume V, is a function of the remaining HMM concentration (Ct) as the experimentally measured variable, as described by Equation (2).
The sorption rate is usually described either as first- or second-order kinetics (Equation (3)), where ki is the kinetic constant at the considered ith order, and qe is the adsorbed metal fraction when reaching equilibrium with the concentration Ce of metal in solution. The integration of Equation (3), under the hypothesis of constant Ce, by considering second-order kinetics gives Equation (4), which relates qt with time. Equation (4) is used to produce a linear plot (t·qt−1) versus t with experimental data that allows the calculation of the two parameters k2 and qe from the intercept and slope.
When the concentration of metal in solution varies with time, the adsorbed fraction at equilibrium qe is usually modelled as a function of liquid equilibrium concentration Ce by the Langmuir or Freundlich isotherm (Equations (5) and (6)). Both functions have two unknown parameters, qmax and KL in the Langmuir equation and KF and n in the Freundlich equation.
The substitution in Equation (3) of qe by Equations (5) or (6), the Langmuir or Freundlich isotherms named here as qe(Ct), and qt by Equation (2) results in the differential Equation (7). This new expression describes the temporal evolution of the concentration in the liquid phase depending on the assumed sorption isotherm model and kinetic order.
For the given set of 3 parameters, Equation (7) was numerically integrated along time and the goodness of the fit to the measured Ct values evaluated as the sum of square errors. A Matlab (version R2017a) routine was used for this purpose to find the parameter values that produced the best fit.
3. Results and Discussion
3.1. The Metallotolerance of Black Fungi
Of the 34 studied BF (Table 1), 28 strains were able to grow on some of the tested concentrations of As(V) and/or Cr(VI) (Table 2). Seventeen strains (50%) displayed measurable growth on agar cultures exposed to As(V) at the maximum tested concentration of 12.5 g of As5+ L−1, while eight strains (23.5%) showed no growth under the minimum tested concentration of 2.5 g of As5+ L−1 (Table 2). The first group of As(V)-tolerant strains primarily belonged to the Chaetothyriales (Cyphellophora olivacea, Exophiala crusticola, E. equina, E. lecanii-corni, E. mesophila, E. oligosperma, E. phaeomuriformis, E. xenobiotica, and Rhinocladiella similis), though some fungi from the Dothidiomycetes were found to be metallotolerant as well (Aulographina pinorum, Aureobasidium melanogenum, Coniosporium uncinatum, and Neohortaea acidophila). A few chaetotyrialean species were also found to be slightly As(V) tolerant (E. angulospora, E. heteromorpha, and Knufia epidermis), but representatives of the order Dothidiomycetes were predominant in this group (Cladosporium herbarum, Scolecobasidium globalis, and Rhizosphaera kalkhoffii). As for Cr(VI), only 5 chaetothyrialean strains (Rhinocladiella similis, Cyphellophora olivacea, Exophiala mesophila, E. crusticola, and E. lecanii-corni) were able to grow at the highest tested concentration of 2.5 g of Cr6+ L−1, while 12 strains showed measurable growth at the lowest tested concentrations of 0.1 g of Cr6+ L−1 (Au. pullulans, C. uncinatum, and Cl. herbarum in the Dothidiomyces; K. epidermis, E. equina, and E. phaeomuriformis in the Chaetothyriales).
Table 2.
Fungal TI and IC50 to As(V) and Cr(VI) after the incubation of agar cultures exposed to the highest and lowest tested concentrations during 30 days. IC50 was estimated by fitting the TI data to a logistic model (r2 > 0.9 unless stated otherwise). The strains from Table 1 that are not shown did not display any growth on the tested As(V) and Cr(VI) concentrations.
The tolerance index (TI) of fungi to the tested concentrations of As(V) and Cr(VI) and the estimated 50% inhibitory concentration of these compounds (IC50) after 30 days of incubation are summarized in Table 2. The 30-day incubated period was taken as an intermediate reference between short-term and long-term toxicity. When considering all incubation times, most fungi showed a negative correlation between TI values and exposure time to high HMM concentrations (Supplementary Table S1), which indicates that HMM toxicity tends to manifest after prolonged incubations. A few chaetothyrialean strains stood out from the rest because of their remarkable level of metallotolerance, such as Exophiala crusticola CCFEE 6188. This particular strain had the highest tolerance to As(V), with average TI values that after 30 days ranged from 1.00 at 2.5 g of As5+ L−1 to 0.50 at 12.5 g of As5+ L−1. The corresponding modelled IC50 estimate was 10.0 g of As5+ L−1. The number of available strains of E. crusticola is relatively small, so little information is available on the ecophysiology of the species. The type strain was isolated from a biological soil crust sample of the Colorado Plateau and Great Basin desert [32]. More recently, this species has also been reported in the Atacama Desert, near Calama in Chile [33], which is among the driest sites in the world and lies close to a large open-pit copper mine. This environment illustrates the polyextremophilic nature of chaetothyrialean fungi to withstand drought, UV radiation, and exposure to toxic metals.
Conversely, the tolerance of E. crusticola CCFEE 6188 to Cr(VI) was lower when compared to other fungi, as it had a TI of 0.73 at 0.1 g of Cr6+ L−1 after 30 days of exposure but it grew scarcely at the higher tested concentrations (its IC50 was 0.56 g of Cr6+ L−1). There were three other strains that displayed a remarkable tolerance to both As(V) and Cr(VI), showing limited inhibition with respect to the control (Figure 1): R. similis CCFEE 6361, C. olivacea CCFEE 6619, and E. mesophila IRTA M2-F10. Their TI values were above 0.4 at the tested concentrations of As(V) and Cr(VI), and the IC50 was in the range of 6–48 g of As5+ L−1, though the latest estimate must be taken with caution as it is well above the highest tested concentration, 0.05–0.25 g of Cr6+ L−1 after 30 days of exposure (Table 2). These strains were generally characterized by TI values at the highest As(V) and Cr(VI) tested concentrations that tended to increase with longer incubation times, up to 60 days (Supplementary Table S1). This phenomenon indicates a progressive longer-term adaptation to HMMs of these particular strains, in contrast to most of the tested BF collection.
Figure 1.
Effect of the concentration of As(V) (top) and Cr(VI) (bottom) on the average and standard deviation (solid bars, n = 6) of the tolerance index (TI) of selected metallotolerant fungal strains, measured from the radial growth in agar cultures after 30 days of incubation. Solid lines correspond to a fitted logistic model for the determination of the IC50 value.
Literature data on the fungal toxicity of HMMs are scarce, particularly with melanized fungi despite their polyextremophilic nature and association to toxic chemicals [21]. There are some reports on the fungal toxicity of arsenic oxyanions, but those have often been performed at a rather low milligram per liter range (between 10 and 500 mg L−1) [34,35,36,37,38]. A few surveys were carried out at the gram per liter range, however. A screening of fungi isolated from arsenic-polluted soil for As(V) tolerance resulted in the selection of five strains, dubbed as “hyper-tolerant”, that had TI values at 10 g of As5+ L−1 that ranged from 0.19 to 0.31 for Aspergillus sp., Neocosmospora sp., Rhizopus sp., and Penicillium sp., and up to 0.96 for an unidentified sterile fungus [15]. Singh et al. [39] reported nine fungal strains that were tolerant to As(V) up to 10 g of As5+ L−1, which belonged to the genera Trichoderma, Aspergillus, Rhizopus, Microdochium, Chaetomium, Myrothecium, Stachybotrys, Rhizomucor, and Fusarium. However, no quantitative tolerance parameters were derived from this study.
Chromium has a complex valence layer that produces different oxidation states that interact with specific nutrients, accentuating the toxicity of this metal [3]. Several previous reports have corroborated the severity of Cr(VI) toxicity to fungi, when compared to As(V). In general, Cr(VI) is more toxic than As(V) to fungi because of its higher reactivity and capacity to generate oxygen reactive species (ROS), which can disrupt several metabolic functions [3,8]. For example, out of 14 isolates from tannery effluents contaminated with Cr(VI), only 1 strain of Trichoderma viride (fam. Hypocreaceae) was able to show some growth at 1 g of Cr6+ L−1 when cultured under laboratory conditions [40]. Other species in this genus have been evaluated for Cr(VI) tolerance, such as a T. harzianum strain isolated from an HMM-polluted mine [41], which displayed a TI at 1 g of Cr6+ L−1 as low as 0.024. Other Aspergillus spp. were also tested in that study (A. sclerotiorum, A. aculeatus, and A. niger) and yielded higher TI values, between 0.12 and 0.67, depending on the strain and the tested Cr(VI) concentration. Another strain of T. viride isolated from tannery wastewaters displayed TI values of 1.15, 0.13, and 0.08, as determined from the biomass production from liquid cultures, after 21 days of incubation with 50, 500, and 1000 mg of Cr6+ L−1 [40]. A second Cr(VI)-tolerant strain identified as Penicillium citrinum showed a similar profile. Interestingly, those fungi seemed to be biostimulated at low concentrations of Cr(VI), both in terms of biomass production and secreted laccase enzymes.
None of the previously mentioned taxa are BF and, in fact, there are few reports quantifying the metallotolerance within this particular group of fungi. The chaetothyrialean Exophiala pisciphila has been isolated repeatedly from the roots of plants growing on soils that are polluted with heavy metals, and in vitro analyses have shown that this fungus tolerates concentrations of Pb(II), Cd(II), and Zn(II) at an IC50 of 0.8, 0.3, and 1.5 g L−1, respectively [42]. Concerning the tolerance to As(V), one study with liquid cultures of different strains of E. sideris isolated from HMM-polluted environments reported IC50 values between 2.0 and 3.7 g of As5+ L−1, depending on the isolate [43]. These latter results are in the As(V) IC50 range found in our study for the strains that belong to the Exophiala genus (Table 2). As for specific accounts on the tolerance of BF to Cr(VI), a minimum inhibitory Cr(VI) concentration of 300 mg of Cr6+ L−1 was determined for the growth of a strain identified as Cladosporium perangustum (fam. Cladosporiaceae) [44].
Some of the BF included in this study encompassed multiple strains from the same species (i.e., two strains of Au. pullulans, C. uncinatum, A. pinorum, E. heteromorpha, E. mesophila, and E. oligosperma, and four of E. xenobiotica and K. epidermis). Comparing growth inhibition patterns among these strains revealed a wide intraspecific variability in their tolerance to HMMs (Table 2). Examples of the most disparate cases include Au. pullulans and C. uncinatum, with one of the two tested strains (CCFEE 6244 and CCFEE 5820) of each species able to grow in the presence of As(V) and Cr(VI), while the other two (CCFEE 5876 and CCFEE 6149) did not show any growth at all. The “hyper-tolerant” E. mesophila strain IRTA M2-F10 also differed significantly from the conspecific CCFEE 5690.
This observation deserves further investigation to verify whether the recorded variability in metal tolerance is intrinsic to the species considered or if it is due to the lack of knowledge in the identification of related species. On the one hand, a detailed molecular analysis could be useful in better determining the position occupied by the two strains within the large group of Au. pullulans. On the other hand, it could be valuable in defining the close relatives of C. uncinatum, which are currently unknown.
On the contrary, metallotolerance appears to be relatively conserved in the four tested strains of E. xenobiotica, which were all able to grow at 12.5 g of As5+ L−1 and displayed IC50 values of 0.7–3 g of As5+ L−1, but none of them grew in the presence of Cr(VI). The two available strains of E. oligosperma displayed a somewhat similar growth pattern in the presence of As(V), with IC50 values of 0.2–2.5 g of As5+ L−1, but neither grew on any of the tested concentrations of Cr(VI). These strains are very similar to each other when comparing their ITS sequences.
At the intragenus level, significant variability in HMM tolerance is also manifested in Exophiala, which, along the observed diverse degrees of metallotolerance, also includes species that, like E. heteromorpha, were consistently unable to grow at any tested concentration of As(V) and Cr(VI). The observed intra- and interspecific differences in HMM tolerance might be attributed to diverse degrees of adaptation to HMM-polluted environments, due to specific genetic changes, epigenetic regulation, and phenotypic adaptations to stressful conditions [30]. Melanization is often cited as a feature that confers tolerance to HMMs because of its capacity to absorb toxic metals [28,45]. However, all tested strains were conspicuously melanized and were isolated from similar environments exposed to toxic chemicals. Hence, besides melanin production and adaptation to toxic environments, other factors must contribute to the tolerance of HMMs in BF. Earlier studies have proposed an array of multiple mechanisms that enable fungi to cope with HMMs [3,46,47], such as reducing the basal energy for metabolism, activating protein protection and DNA repair against oxidative stress, enhancing iron and sulfur acquisition, transforming metal species to less toxic or volatile metabolites, detoxifying free radicals, and through homeostasis.
Exposure to As(V) and Cr(VI) caused macroscopic morphological changes in fungal growth that were visible on agar colonies, as shown in Figure 2 for the metallotolerant R. similis CCFEE 6361, C. olivacea CCFEE 6619, and E. mesophila IRTA M2-F10. Fungal biomass tended to display a stronger dark pigmentation upon metal exposure, which might be attributable to an increased level of melanin biosynthesis as a defensive mechanism. A few strains like those of E. mesophila also formed colonies that were irregular in shape and displayed coarser edges under stressful conditions, a phenomenon known as meristematic growth. This morphological plasticity has also been observed with E. oligosperma CCFEE 6327 when grown at 35 °C under laboratory conditions, a temperature close to its upper temperature growth limit [48]. A similar morphology is also manifested in the case of opportunistic mammal infections, defined then as muriform cells [49]. The isodiametric growth and the aggregated, compact shape of fungal microcolonies ensure the optimal surface/volume ratio, minimizing the direct exposure to external stressors [50]. This type of growth is also expressed as an adaptation in the closely related lithobiontic black fungi (known as rock-inhabiting fungi, RIF) [51].
Figure 2.
Macromorphological effects of the exposure to increasing concentrations of As(V) and Cr(VI) on fungal agar cultures of the metallotolerant black fungi.
3.2. Biosorption Assays
Two of the strains screened previously for metallotolerance, R. similis CCFEE 6361 and E. mesophila IRTA M2-F10, were selected for subsequent biosorption experiments because of their intrinsic tolerance to both As(V) and Cr(VI) and for their easy cultivation in liquid media for producing biomass. After 30 days of incubation of pre-grown fungal liquid cultures with As(V) and Cr(VI) (approx. 50 mg of DM L−1; an initial HMM concentration of 20 mg L−1), the HMM content remaining in the supernatant was measured (Table 3). From these results, it was evident that BF biomass had a comparatively low absorption capacity for As(V) when compared to Cr(VI), as removal efficiencies for the first did not exceed 10%, while for the second, they were higher than 80% under similar test conditions.
Table 3.
Fungal HMM biosorption capacity and removal efficiency. Incubations lasted 30 days, and results are expressed as the average and standard deviation of three independent experiments. One-way ANOVA comparisons were performed on the specific removal capacity for every metal, and non-significant differences are indexed (n = 3; p < 0.05). Significance letters for the Tukey test were added to the specific removal capacity data.
The specific As(V) removal capacity of living cultures of E. mesophila and R. similis incubated for 30 days at pH 6.5 was 1.07 and 1.34 mg of As5+ g DM−1. The difference between the two fungi was not statistically significant (p > 0.05). However, the biosorption of As(V) by heat-inactivated biomass of E. mesophila was significantly lower than that by living cultures of the same fungus. Despite the apparently modest As(V) biosorption results with the tested BF, previous similar studies with this metalloid have yielded even lower numbers. Different fungal species in the genera Neocosmospora, Sordaria, Rhizopus, and Penicillium displayed biosorption capacities that ranged from 0.009 to 0.016 mg As5+ g DM−1 [15]. Other authors claimed that cultures of fungi belonging to Aspergillus, Fusarium, Rhizomucor, and Emericella were able to absorb between 0.023 and 0.259 mg As5+ g DM−1 depending on the strain [39]. Those experiments were performed within the pH range of 4–7 used in our study, and all used strains correspond to fungi that are not conspicuously melanized. Hence, fungal melanization might indeed improve As(V) biosorption by cultures of BF.
Fungal biosorption patterns changed completely when Cr(VI) was used. Equivalent incubations with this metal showed that the specific removal capacity after 30 days of incubation was slightly higher for E. mesophila (12.57 mg Cr6+ g DM−1) than for R. similis (11.50 g Cr6+ mg DM−1). As with As(V), the heat inactivation of cultures of E. mesophila caused a reduction in the biosorption capacity (9.59 g Cr6+ mg DM−1). However, differences in the specific Cr(VI) biosorption capacity in all tested fungi and incubation conditions were statistically not significant (p > 0.05). Previous reports on the specific Cr(VI) biosorption capacity of fungi correspond primarily to modified biomass, and relatively few records with living fungal cultures are available. Some fungi isolated from samples of sludge and industrial effluents contaminated with heavy metals (Trichoderma viride, T. longibrachiatum, Aspergillus niger, and Phanerochaete chrysosporium) displayed biosorption capacities that ranged from 0.03 to 0.55 mg Cr6+ g DM−1 when incubated (150 rpm at 28 °C) with potato dextrose broth containing 50 mg Cr6+ L−1 for 4 days [52]. Lotlikar et al. [53] isolated three strains from Arabian Sea sediments, identified as Purpureocillium lilacinum, Aspergillus sydowii, and A. terreus, that were able to grow with 300 mg Cr6+ L−1 (pH 5, shaken conditions, and room temperature) and biosorbed 8, 10, and 13 mg Cr6+ g DM−1, respectively, after 20 days of incubation. Reports on Cr(VI) biosorption by BF are very limited; liquid cultures of Aureobasidium pullulans growing on the acid hydrolysate of peat containing HMMs (200 rpm; 26 °C; pH 6.0) were able to absorb 0.77 mg Cr6+ g DM−1 after 160 h of incubation [54].
The sorption of As(V) and Cr(VI) onto organic materials has been described as a pH-dependent phenomenon [55,56]. At acidic conditions, As(V) exists primarily in the form of dihydrogen arsenate (H2AsO4−), while Cr(VI) is present as chromate (CrO42−). As the pH increases, H2AsO4− transforms into hydrogen arsenate (HAsO42−) or arsenate (AsO43−) and CrO42− transforms into dichromate (Cr2O72−), resulting in an increase in the net negative charge. The pH also influences the surface charge of the sorbent, so the point of zero charge (pzc)—the pH at which the net charge of the total absorbent’s surface is equal to zero—for fungal biomass is in the range of pH 4.0–4.5 [57,58]. Above these pH values, the surface becomes negatively charged, exacerbating its electrostatic repulsion towards As(V) and Cr(VI) anions. Interestingly, fungal incubations at pH 4.0 significantly (p < 0.05) enhanced the biosorption of Cr(VI), but not that of As(V), compared to analogous experiments at pH 6.5 (Table 3).
The HMM biosorption capacity of heat-inactivated biomass of E. mesophila was lower than with equivalent viable cultures (Table 3). Several investigations on the passive adsorption process on the cell surface have been performed using dead fungal biomass [59,60,61]. It has been claimed that the biosorption of dried biomass increases the contact surface between HMMs and the metal binding sites of the fungal cell wall [62]. However, heat-inactivated biomass may still keep the structures of the fungal cell relatively intact. A comparison between living cultures and dried pulverized biomass of a group of fungi (Aspergillus foetidus, A. niger, A. terricola, Acremonium strictum, Paecilomyces variotii, Phanerochaete chrysosporium, Aureobasidium pullulans, and Cladosporium resinae) claimed that while the Cr(VI) biosorption capacity in the first ranged from 0.1 to 3.0 mg Cr6+ g−1-DM, in the second, it increased up to 11.2 mg Cr6+ g−1-DM (pH 3; 100 rpm; 28.1 °C) [63]. Literature accounts on the use of inactivated fungal biomass as HMM sorbents have often included the addition of specific coadjuvants that mitigate the electrostatic repulsion between the sorbent and sorbate. A Penicillium chrysogenum was modified with three different surfactants (amines) to increase the removal capacities of modified biomass from 37.85 to 56.07 mg As5+ g−1 at pH 3 [64].
3.3. Biosorption Isotherms and Kinetics
The differential Equation (7) describing the first- and second-order kinetics, integrating the Langmuir and Freundlich isotherms, was fitted to experimental data on the time-course evolution of metal concentration in the supernatant. Changes with As(V) were too subtle to fit any sorption model with enough confidence, but the experimental data on the time-course depletion of Cr(VI) showed that the best fits were obtained with second-order sorption kinetics and the Langmuir sorption isotherm (Figure 3). Previous similar studies that compared different models to describe the fungal biosorption of metals showed that the Langmuir isotherm and second-order sorption kinetics displayed the best coefficients of determination [65,66,67]. The Langmuir isotherm is a theoretical approximation that considers a finite monolayer of available adsorption sites onto a homogeneous surface. This assumption implies that the sorbent has a limited surface-dependent maximum theoretical sorption capacity (qmax), and that there is neither interaction nor transmigration of metal ions after monolayer adsorption.
Figure 3.
Fits of experimental data of Cr(VI) biosorption on living cultures (pH 6.5) of Rhinocladiella similis (left) and Exophiala mesophila (right) to the second-order kinetics and the Langmuir isotherm model (differential Equation (7)). Experimental data correspond to the average and standard deviation of three replicates.
The fitted parameters of Langmuir isotherms and second-order kinetics for the biosorption of Cr(VI) with the tested BF are summarized and compared with bibliographic data in Table 4. The “theoretical” maximum sorption capacity qmax of R. similis and E. mesophila (39.81 and 95.26 mg Cr+6 g DM−1) is above those seen previously with several other non-melanized fungi in analogous experiments. Most of those assays were performed with inactivated/modified fungal biomass and at a low pH, conditions that might favor biosorption, but under which process scaling-up into practical applications is challenging. In what concerns the half-saturation concentration (the metal concentration in equilibrium at which the biosorbed metal equals half of qmax), which is the reverse of the affinity constant KL, both tested BF displayed rather similar values of 8.90 and 5.09 mg Cr6+ L−1, respectively, for R. similis and E. mesophila. The affinity to Cr(VI) of biomass from hyaline species tested previously is quite low in general when compared to BF (Table 4).
The second-order kinetic constant k2, which corresponds to the specific biosorption rate, is one order of magnitude lower for E. mesophila when compared to R. similis, 1.39 × 10−7 versus 1.32 × 10−6 g DM (mg Cr6+ min)−1. The higher qmax and lower k2 of E. mesophila when compared to R. similis could be related to the higher Cr(VI) tolerance of the former over the latter (Table 2). Several previous accounts on the second-order kinetics of Cr(VI) biosorption by non-melanogenic fungi have reported k2 values above 10−2 g DM (mg Cr6+ min)−1 (Table 4). Interestingly, previous studies with melanized fungal structures, like lyophilized cells of the BF Cladosporium cladosporioides and spores of Aspergillus niger, also yielded comparatively low biosorption rates and high substrate affinity.
In order to gain a deeper insight into the role of fungal melanin when exposed to Cr(VI), biosorption experiments were repeated with melanin extracts from E. mesophila (Figure 4). The obtained fitted parameter values are between 1 and 2 orders of magnitude higher than those measured with living cultures of the same fungus (qmax = 544.84 mg Cr6+ g DM−1; KL = 0.0075 L mg−1; and k2 = 1.67 × 10−6 g DM (mg Cr6+ min)−1). Considering that the mass of the extracted melanin corresponded to 12.5% of the fungal biomass, on a dry matter basis (125 mg g DM−1), the potential contribution of melanin to the biosorption capacity of whole cells could be as high as 71.5%. These results confirm that fungal melanin plays a vital role in the biosorption of HMMs. Furthermore, the qmax of melanin is well above that of several tested Cr(VI) organic absorbents, from raw and modified lignocellulosic materials [68] to advanced carbon nanomaterials [69].
Figure 4.
Fit of experimental data of Cr(VI) biosorption on melanin extracts of Exophiala mesophila to the second-order kinetics and the Langmuir isotherm model (differential Equation (7)). Experimental data correspond to the average and standard deviation of three replicates.
Table 4.
Fitted parameters for modelling the biosorption of Cr(VI) using the second-order kinetic model and/or the Langmuir isotherm by different fungal species.
Table 4.
Fitted parameters for modelling the biosorption of Cr(VI) using the second-order kinetic model and/or the Langmuir isotherm by different fungal species.
| Fungus a | pH | C (mg L−1) | Fitted Equation | Model Parameters | Source | |||
|---|---|---|---|---|---|---|---|---|
| k2 (g (mg min)−1) | qmax (mg g−1) | KL (L mg−1) | r2 | |||||
| Rhinocladiella similis (CS) | 6.5 | 25 | Equation (7) | 1.32 × 10−6 | 39.81 | 0.1124 | 0.977 | This study |
| Exophiala mesophila (CS) | 6.5 | 25 | Equation (7) | 1.39 × 10−7 | 95.26 | 0.1964 | 0.924 | This study |
| Exophiala mesophila (MEs) | 6.5 | 25 | Equation (7) | 1.67 × 10−6 | 544.84 | 0.0075 | 0.969 | This study |
| Cladosporium cladosporioides (LB) | 2.0 | 25 | Equation (4) | 7.50 × 10−5 | 28.90 | – | 0.991 | [70] |
| Aspergillus niger (SS) | 2.0 | 100 | Equation (4) | 5.76 × 10−4 | 56.15 | – | 0.994 | [71] |
| Equation (5) | – | 47.33 | 0.5416 | 0.999 | ||||
| Aspergillus niger (DB) | 2.0 | 27 | Equation (4) | 3.38 | 6.45 | – | 0.998 | [67] |
| Equation (5) | – | 71.9 | 0.031 | 0.999 | ||||
| Lentinus sajor-caju (CS) | 2.0 | 30 | Equation (4) | 3.39 × 10−2 | 20.80 | – | 0.994 | [72] |
| Equation (5) | – | 23.32 | 0.0133 | 0.993 | ||||
| Ustilago maydis (DB) | 5.5–6.5 | 25 | Equation (4) | 1.37 × 10−2 | 1.95 | – | ns b | [73] |
| Equation (5) | – | 17.16 | 0.0090 | 0.965 | ||||
| Mucor hiemalis (DB) | 2.0 | 100 | Equation (4) | 5.5 × 10−1 | 30.5 | – | 0.993 | [74] |
| Equation (5) | – | 47.4 | 0.0307 | 0.999 | ||||
| Ganoderma applanatum (DB) | 2.0 | 25 | Equation (4) | 7.4 × 10−1 | 16.13 | – | 0.999 | [75] |
| Equation (5) | – | 200 | 0.002 | 0.999 | ||||
| Rhizopus sp. (DB) | 2.0 | 25 | Equation (4) | 1.13 × 10−2 | 5.4509 | – | 0.986 | [65] |
| Equation (5) | – | 8.0589 | 0.7730 | 0.841 | ||||
a fungal species and pre-treatment of the biomass: living cell suspension (CS); melanin extracts (MEs); lyophilized biomass (LB); spore suspension (SS); dead biomass (DB). b not determined/not shown.
The results from this study are consistent with the hypothesis that fungal melanin plays an active role in the biosorption of toxic HMM, such as As(V) and Cr(VI). Melanin is an amorphous polymeric structure that concentrates in the fungal cell wall and offers a great number of heterogeneous binding sites to the sorption of metal ions [28]. Melanin is also a conductive material that mediates electron transport between fungal biomass and the solute, which might contribute to chemisorption by sharing or exchanging electrons between the sorbent and sorbate [76]. A previous study on the binding of copper by melanin extracts, intact cells, and albino mutants of the BF Cladosporium resinae and Aureobasidium pullulans demonstrated that the metal uptake capacity was higher in melanin extracts, followed by intact cells and, finally, in albino cells [77].
However, other studies have disputed the role of melanin as a metal biosorbent. An early study found no significant differences in the binding of copper by cultures of the melanized plant pathogen Gaeumannomyces graminis, either grown at low concentrations of this metal or additionally supplemented with tricyclazole, an inhibitor of DHN-melanin [78]. More recently, it has been proposed that melanin may have a role in binding metals and protecting fungi from toxic metals, but the main mechanisms might not necessarily be related to sorption processes [79,80]. Potisek [80] used different strains of dark septate endophytes of Cadophora spp., with different melanin contents, to investigate their tolerance to cadmium. The melanin content was positively correlated with a higher cadmium tolerance, but the accumulation of this metal was not. More contentious studies on Exophiala pisciphila even claimed that the inhibition of melanization in this fungus did not cause any remarkable effect on the tolerance of metal ions [43].
Indeed, the high inter- and intraspecific variability in metallotolerance observed among the studied black fungi (Table 2) suggest that there must be other physiologic mechanisms to cope with the toxic effects of toxic metals and metalloids, rather than relying solely on melanization. In this regard, the comparatively high biosorption capacity of BF to HMMs, in combination with low sorption rates, could be the result of an evolved strategy to, firstly, minimize the penetration of toxic metals into the cell and, secondly, sequester those that would eventually leak into the cytoplasm.
4. Conclusions
Several published studies have revealed that fungal biomass has good performance as a biosorbent of heavy metals and metalloids, in comparison to commercial materials such as ion exchange resins, activated carbon, and metal oxides. Fungal biosorption depends on parameters such as the used fungi and metal species but also the pH, temperature, biomass pre-treatments, and the presence of various ligands in solution. The fungal cell wall fraction seems to play an important role in the sorption of heavy metals, though the biosorption mechanisms are understood only to a limited extent. The ability of fungi to tolerate and biosorb specific heavy metals and metalloids has previously been evaluated and reviewed, as is the case for As(V) and Cr(VI), but the literature on the metallotolerance of extremophilic black fungi is still comparatively scarce.
To our knowledge, the present work provides the first in-depth survey of the metallotolerance of a strain collection of BF isolated previously from polluted sites. The obtained results indicate that there is broad inter- and intraspecific variability in metallotolerance, using As(V) and Cr(VI) as model HMMs. Living cultures of two hyper-metallotolerant strains of Rhinocladiella similis and Exophiala mesophila displayed a significant biosorption capacity but, conversely, sorption rates were comparatively slow in relation to other non-black fungi. This phenomenon could be explained by the interplay of two protective processes: an outer cell wall barrier and the inner cell wall biosorption of leaked metals and metalloids by melanin. These findings might contribute to the development of future strategies for the bioremediation of HMM pollution and need to be further investigated. Black fungi could also be valuable bioindicators of HMMs in natural and anthropogenic environments.
Supplementary Materials
The following supporting information can be downloaded at: https://www.mdpi.com/article/10.3390/jof10010047/s1, Table S1_Metallotoletance.
Author Contributions
Individual contributions to this study are indicated with the authors’ initials: Conceptualization, C.M.-A. and F.X.P.-B.; methodology, C.M.-A. and A.P.; software, C.M.-A. and J.I.; validation, J.I. and F.X.P.-B.; formal analysis, C.M.-A. and F.X.P.-B.; investigation, C.M.-A. and F.X.P.-B.; resources, D.I. and M.V.; writing—original draft preparation, C.M.-A.; writing—review and editing, F.X.P.-B., J.I. and D.I.; supervision, F.X.P.-B. All authors have read and agreed to the published version of the manuscript.
Funding
This research has been partly funded by the project AGAUR (Generalitat de Catalunya) through the Consolidated Research Group SOSBIO (ref. 2021 SGR 01568). Cristy Medina-Armijo was a recipient of the grant ANID Chile.
Institutional Review Board Statement
Not applicable.
Informed Consent Statement
Not applicable.
Data Availability Statement
All data of this research are reported in the main text and Supplementary material.
Acknowledgments
We acknowledge Alexia Douillard, from the University of Angers, and Marta Manyà, from the Autonomous University of Barcelona, for laboratory assistance during her undergraduate internship. This research was supported by the CERCA Programme/Generalitat de Catalunya.
Conflicts of Interest
The authors declare no conflicts of interest.
References
- Zhang, Q.; Wang, C. Natural and human factors affect the distribution of soil heavy metal pollution: A Review. Water. Air. Soil. Pollut. 2020, 231, 1–13. [Google Scholar] [CrossRef]
- Siddiquee, S.; Saallah, S.; Rovina, K.; Al Azad, S.; Naher, L.; Suryani, S.; Chaikaew, P. Heavy metal contaminants removal from wastewater using the potential filamentous fungi biomass: A review. Artic. J. Microb. Biochem. Technol. 2015, 7, 384–393. [Google Scholar] [CrossRef]
- Viti, C.; Marchi, E.; Decorosi, F.; Giovannetti, L. Molecular mechanisms of Cr (VI) resistance in bacteria and fungi. FEMS Microbiol. Rev. 2014, 38, 633–659. [Google Scholar] [CrossRef]
- Podgorski, J.; Berg, M. Global threat of arsenic in groundwater. Science 2020, 368, 845–850. [Google Scholar] [CrossRef]
- WHO/SDE/WSH/03.04/75; Arsenic in Drinking-Water—Background Document for Development of WHO Guidelines for Drinking-Water Quality. World Health Organization: Geneva, Switzerland, 2019.
- Sappa, G.; Ergul, S.; Ferranti, F. Geochemical modeling and multivariate statistical evaluation of trace elements in arsenic contaminated groundwater systems of Viterbo area, (Central Italy). SpringerPlus 2014, 3, 237. [Google Scholar] [CrossRef]
- Tumolo, M.; Ancona, V.; De Paola, D.; Losacco, D.; Campanale, C.; Massarelli, C.; Uricchio, V.F. Chromium pollution in European water, sources, health risk, and remediation strategies: An overview. Int. J. Environ. Res. Public. Health 2020, 17, 5438. [Google Scholar] [CrossRef]
- Sun, Q.; Li, Y.; Shi, L.; Hussain, R.; Mehmood, K.; Tang, Z.; Zhang, H. Heavy metals induced mitochondrial dysfunction in animals: Molecular mechanism of toxicity. Toxicology 2022, 469, 153136. [Google Scholar] [CrossRef]
- Fu, F.; Wang, Q. Removal of heavy metal ions from wastewaters: A review. J. Environ. Manag. 2011, 92, 407–418. [Google Scholar] [CrossRef]
- Costa, F.; Tavares, T. Bioremoval of Ni and Cd in the presence of diethylketone by fungi and by bacteria—A comparative study. Int. Biodeterior. Biodegrad. 2017, 120, 115–123. [Google Scholar] [CrossRef]
- Kang, C.H.; Kwon, Y.J.; So, J.S. Bioremediation of heavy metals by using bacterial mixtures. Ecol. Eng. 2016, 89, 64–69. [Google Scholar] [CrossRef]
- Zeraatkar, A.K.; Ahmadzadeh, H.; Talebi, A.F.; Moheimani, N.R.; McHenry, M.P. Potential use of algae for heavy metal bioremediation, a critical review. J. Environ. Manag. 2016, 181, 817–831. [Google Scholar] [CrossRef]
- Ali, S.; Abbas, Z.; Rizwan, M.; Zaheer, I.E.; Yavas, I.; Ünay, A.; Abdel-Daim, M.M.; Bin-Jumah, M.; Hasanuzzaman, M.; Kalderis, D. Application of floating aquatic plants in phytoremediation of heavy metals polluted water: A review. Sustainability 2020, 12, 1927. [Google Scholar] [CrossRef]
- Acosta-Rodríguez, I.; Cardenás-González, J.F.; Pérez, A.S.R.; Oviedo, J.T.; Martínez-Juárez, V.M. Bioremoval of different heavy metals by the resistant fungal strain Aspergillus niger. Bioinorg. Chem. Appl. 2018, 2018, 3457196. [Google Scholar] [CrossRef]
- Srivastava, P.K.; Vaish, A.; Dwivedi, S.; Chakrabarty, D.; Singh, N.; Tripathi, R.D. Biological removal of arsenic pollution by soil fungi. Sci. Total Environ. 2011, 409, 2430–2442. [Google Scholar] [CrossRef]
- da Silva, N.M.; Reis, G.F.; Costa, F.D.F.; Grisolia, M.E.; Geraldo, M.R.; Lustosa, B.P.R.; Lima, B.J.F.D.S.; Weiss, V.A.; de Souza, E.M.; Li, R.; et al. Genome sequencing of Cladophialophora exuberans, a novel candidate for bioremediation of hydrocarbon and heavy metal polluted habitats. Fungal Biol. 2023, 127, 1032–1042. [Google Scholar] [CrossRef]
- Oh, J.J.; Kim, J.Y.; Kim, Y.J.; Kim, S.; Kim, G.H. Utilization of extracellular fungal melanin as an eco-friendly biosorbent for treatment of metal-contaminated effluents. Chemosphere 2021, 272, 129884. [Google Scholar] [CrossRef]
- Teixeira, M.M.; Moreno, L.F.; Stielow, B.J.; Muszewska, A.; Hainaut, M.; Gonzaga, L.; Abouelleil, A.; Patané, J.S.L.; Priest, M.; Souza, R.; et al. Exploring the genomic diversity of black yeasts and relatives (Chaetothyriales, Ascomycota). Stud. Mycol. 2017, 86, 1–28. [Google Scholar] [CrossRef]
- Selbmann, L.; Egidi, E.; Isola, D.; Onofri, S.; Zucconi, L.; de Hoog, G.S.; Chinaglia, S.; Testa, L.; Tosi, S.; Balestrazzi, A.; et al. Biodiversity, evolution and adaptation of fungi in extreme environments. Plant Biosyst. 2013, 147, 237–246. [Google Scholar] [CrossRef]
- Selbmann, L.; Isola, D.; Fenice, M.; Zucconi, L.; Sterflinger, K.; Onofri, S. Potential extinction of antarctic endemic fungal species as a consequence of global warming. Sci. Total Environ. 2012, 438, 127–134. [Google Scholar] [CrossRef]
- Isola, D.; Selbmann, L.; de Hoog, G.S.; Fenice, M.; Onofri, S.; Prenafeta-Boldú, F.X.; Zucconi, L. Isolation and screening of black fungi as degraders of volatile aromatic hydrocarbons. Mycopathologia 2013, 175, 369–379. [Google Scholar] [CrossRef]
- Prenafeta-Boldú, F.X.; de Hoog, G.S.; Summerbell, R.C. Fungal communities in hydrocarbon degradation. In Microbial Communities Utilizing Hydrocarbons and Lipids: Members, Metagenomics and Ecophysiology; Handbook of Hydrocarbon and Lipid Microbiology; McGenity, T., Ed.; Springer: Berlin/Heidelberg, Germany, 2019; pp. 1–36. [Google Scholar]
- Abdollahzadeh, J.; Groenewald, J.Z.; Coetzee, M.P.A.; Wingfield, M.J.; Crous, P.W. Evolution of lifestyles in Capnodiales. Stud. Mycol. 2020, 95, 381. [Google Scholar] [CrossRef]
- Butler, M.J.; Gardiner, R.B.; Day, A.W. Fungal melanin detection by the use of copper sulfide-silver. Mycologia 2005, 97, 312–319. [Google Scholar] [CrossRef]
- Prota, G. Melanins and Melanogenesis; Academic Press: San Diego, CA, USA, 1992. [Google Scholar]
- Kumar, C.G.; Mongolla, P.; Pombala, S.; Kamle, A.; Joseph, J. Physicochemical characterization and antioxidant activity of melanin from a novel strain of Aspergillus bridgeri ICTF-201. Lett. Appl. Microbiol. 2011, 53, 350–358. [Google Scholar] [CrossRef]
- Fogarty, R.V.; Tobin, J.M. Fungal melanins and their interactions with metals. Enzym. Microb. Technol. 1996, 19, 311–317. [Google Scholar] [CrossRef]
- Isola, D.; Scano, A.; Orrù, G.; Prenafeta-Boldú, F.X.; Zucconi, L. Hydrocarbon-Contaminated sites: Is there something more than Exophiala xenobiotica? New insights into black fungal diversity using the long cold incubation method. J. Fungi 2021, 7, 817. [Google Scholar] [CrossRef]
- Isola, D.; Zucconi, L.; Cecchini, A.; Caneva, G. Dark-pigmented biodeteriogenic fungi in etruscan hypogeal tombs: New data on their culture-dependent diversity, favouring conditions, and resistance to biocidal treatments. Fungal Biol. 2021, 125, 609–620. [Google Scholar] [CrossRef]
- Selvakumar, P.; Rajasekar, S.; Periasamy, K.; Raaman, N. Isolation and characterization of melanin pigment from Pleurotus cystidiosus (telomorph of antromycopsis macrocarpa). World J. Microbiol. Biotechnol. 2008, 24, 2125–2131. [Google Scholar] [CrossRef]
- Suwannarach, N.; Kumla, J.; Watanabe, B.; Matsui, K.; Lumyong, S. Characterization of melanin and optimal conditions for pigment production by an endophytic fungus, Spissiomyces endophytica SDBR-CMU319. PLoS ONE 2019, 14, e0222187. [Google Scholar] [CrossRef]
- Bates, S.T.; Reddy3, G.S.N.; Garcia-Pichel, F. Exophiala crusticola Anam. Nov. (affinity Herpotrichiellaceae), a novel black yeast from biological soil crusts in the western United States. Int. J. Syst. 2006, 56, 2697–2702. [Google Scholar] [CrossRef][Green Version]
- Madrid, H.; Gené, J.; Quijada, L.; Cantillo, T.; Gacitúa, R.; Valdés, J.; Sánchez, C.; Prenafeta-Boldú, F.; Wijayawardene, N.; Silva, V.; et al. Exophiala atacamensis sp. nov. and E. crusticola from the Atacama desert, northern Chile. Sydowia 2023, 75, 181–192. [Google Scholar]
- Vala, A.K. Tolerance and removal of arsenic by a facultative marine fungus Aspergillus candidus. Bioresour. Technol. 2010, 101, 2565–2567. [Google Scholar] [CrossRef]
- Mukherjee, A.; Das, D.; Kumar Mondal, S.; Biswas, R.; Kumar Das, T.; Boujedaini, N.; Khuda-Bukhsh, A.R. Tolerance of arsenate-induced stress in Aspergillus niger, a possible candidate for bioremediation. Ecotoxicol. Environ. Saf. 2010, 73, 172–182. [Google Scholar] [CrossRef]
- Nam, I.H.; Murugesan, K.; Ryu, J.; Kim, J.H. Arsenic (As) removal using Talaromyces sp. KM-31 isolated from As-contaminated mine soil. Minerals 2019, 9, 568. [Google Scholar] [CrossRef]
- Ceci, A.; Spinelli, V.; Massimi, L.; Canepari, S.; Persiani, A.M. Fungi and arsenic: Tolerance and bioaccumulation by soil saprotrophic species. Appl. Sci. 2020, 10, 3218. [Google Scholar] [CrossRef]
- Oladipo, O.G.; Awotoye, O.O.; Olayinka, A.; Bezuidenhout, C.C.; Maboeta, M.S. Heavy metal tolerance traits of filamentous fungi isolated from gold and gemstone mining sites. Braz. J. Microbiol. 2018, 49, 29–37. [Google Scholar] [CrossRef]
- Singh, M.; Srivastava, P.K.; Verma, P.C.; Kharwar, R.N.; Singh, N.; Tripathi, R.D. Soil fungi for mycoremediation of arsenic pollution in agriculture soils. J. Appl. Microbiol. 2015, 119, 1278–1290. [Google Scholar] [CrossRef]
- Zapana-Huarache, S.V.; Romero-Sánchez, C.K.; Gonza, A.P.D.; Torres-Huaco, F.D.; Rivera, A.M.L. Chromium (VI) Bioremediation potential of filamentous fungi isolated from Peruvian Tannery industry effluents. Braz. J. Microbiol. 2020, 51, 271–278. [Google Scholar] [CrossRef]
- Liaquat, F.; Munis, M.F.H.; Haroon, U.; Arif, S.; Saqib, S.; Zaman, W.; Khan, A.R.; Shi, J.; Che, S.; Liu, Q. Evaluation of metal tolerance of fungal strains isolated from contaminated mining soil of Nanjing, China. Biology 2020, 9, 469. [Google Scholar] [CrossRef]
- Zhang, Y.; Zhang, Y.; Liu, M.; Shi, X.; Zhao, Z. Dark septate endophyte (DSE) fungi isolated from metal polluted soils: Their taxonomic position, tolerance, and accumulation of heavy metals in vitro. J. Microbiol. 2008, 46, 624–632. [Google Scholar] [CrossRef]
- Seyedmousavi, S.; Badali, H.; Chlebicki, A.; Zhao, J.; Prenafeta-boldú, F.X.; De Hoog, G.S. Exophiala sideris, a novel black yeast isolated from environments polluted with toxic alkyl benzenes and arsenic. Fungal Biol. 2011, 115, 1030–1037. [Google Scholar] [CrossRef]
- Sharma, S.; Malaviya, P. Bioremediation of Tannery wastewater by chromium resistant novel fungal consortium. Ecol. Eng. 2016, 91, 419–425. [Google Scholar] [CrossRef]
- Fomina, M.; Gadd, G.M. Metal sorption by biomass of melanin-producing fungi grown in clay-containing medium. J. Chem. Technol. Biotechnol. 2003, 78, 23–34. [Google Scholar] [CrossRef]
- Liu, S.; Chen, M.; Cao, X.; Li, G.; Zhang, D.; Li, M.; Meng, N.; Yin, J.; Yan, B. Chromium (VI) removal from water using cetylpyridinium chloride (CPC)-modified montmorillonite. Sep. Purif. Technol. 2020, 241, 116732. [Google Scholar] [CrossRef]
- Acevedo-Aguilar, F.J.; Espino-Saldaña, A.E.; Leon-Rodriguez, I.L.; Rivera-Cano, M.E.; Avila-Rodriguez, M.; Wrobel, K.; Wrobel, K.; Lappe, P.; Ulloa, M.; Gutiérrez-Corona, J.F. Hexavalent chromium removal in vitro and from industrial wastes, using chromate-resistant strains of filamentous fungi indigenous to contaminated wastes. Can. J. Microbiol. 2006, 52, 809–815. [Google Scholar] [CrossRef]
- Isola, D.; Bartoli, F.; Meloni, P.; Caneva, G.; Zucconi, L. Black fungi and stone heritage conservation: Ecological and metabolic assays for evaluating colonization potential and responses to traditional biocides. Appl. Sci. 2022, 12, 2038. [Google Scholar] [CrossRef]
- Seyedmousavi, S.; Netea, M.G.; Mouton, J.W.; Melchers, W.J.G.; Verweij, P.E.; de Hoog, G.S. Black yeasts and their filamentous relatives: Principles of pathogenesis and host defense. Clin. Microbiol. Rev. 2014, 27, 527–542. [Google Scholar] [CrossRef]
- Harutyunyan, S.; Muggia, L.; Grube, M. Black fungi in lichens from seasonally arid habitats. Stud. Mycol. 2008, 61, 83. [Google Scholar] [CrossRef]
- Sterflinger, K.; De Hoog, G.S.; Haase, G. Phylogeny and ecology of meristematic Ascomycetes. Stud. Mycol. 1999, 1999, 5–22. [Google Scholar]
- Joshi, P.K.; Swarup, A.; Maheshwari, S.; Kumar, R.; Singh, N. Bioremediation of heavy metals in liquid media through fungi isolated from contaminated sources. Indian J. Microbiol. 2011, 4, 482–487. [Google Scholar] [CrossRef]
- Lotlikar, N.P.; Damare, S.R.; Meena, R.M.; Linsy, P.; Mascarenhas, B. Potential of marine-derived fungi to remove hexavalent chromium pollutant from culture broth. Indian J. Microbiol. 2018, 2, 182–192. [Google Scholar] [CrossRef]
- Radulović, M.D.; Cvetković, O.G.; Nikolić, S.D.; Dordević, D.S.; Jakovljević, D.M.; Vrvić, M.M. Simultaneous production of pullulan and biosorption of metals by Aureobasidium pullulans strain CH-1 on peat hydrolysate. Bioresour. Technol. 2008, 14, 6673–6677. [Google Scholar] [CrossRef] [PubMed]
- Unceta, N.; Séby, F.; Malherbe, J.; Donard, O.F.X. Chromium speciation in solid matrices and regulation: A review. Anal. Bioanal. Chem. 2010, 397, 1097–1111. [Google Scholar] [CrossRef] [PubMed]
- Chiban, M.; Zerbet, M.; Carja, G.; Sinan, F. Application of low-cost adsorbents for arsenic removal: A Review. J. Environ. Chem. Ecotoxicol. 2012, 4, 91–102. [Google Scholar] [CrossRef]
- Mohamed, L.A.; Aniagor, C.O.; Taha, G.M.; Abou-Okeil, A.; Hashem, A. Mechanistic investigation of the mass transfer stages involved during the adsorption of aqueous lead onto Scopulariopsis brevicompactum fungal biomass. Environ. Chall. 2021, 5, 100373. [Google Scholar] [CrossRef]
- Long, D.-D.; Wang, Q.; Han, J.-R. Biosorption of copper (II) from aqueous solutions by sclerotiogenic Aspergillus oryzae G15. Water Environ. Res. 2017, 89, 703–713. [Google Scholar] [CrossRef]
- Benila Smily, J.R.M.; Sumithra, P.A. Optimization of chromium biosorption by fungal adsorbent, Trichoderma sp. BSCR02 and its desorption studies. Hayati J. Biosci. 2017, 24, 65–71. [Google Scholar] [CrossRef]
- Velmurugan, P.; Shim, J.; You, Y.; Choi, S.; Kamala-Kannan, S.; Lee, K.J.; Kim, H.J.; Oh, B.T. Removal of zinc by live, dead, and dried biomass of Fusarium spp. Isolated from the abandoned-metal mine in South Korea and its perspective of producing nanocrystals. J. Hazard. Mater. 2010, 182, 317–324. [Google Scholar] [CrossRef]
- Shroff, K.A.; Vaidya, V.K. Kinetics and equilibrium studies on biosorption of nickel from aqueous solution by dead fungal biomass of Mucor hiemalis. Chem. Eng. J. 2011, 171, 1234–1245. [Google Scholar] [CrossRef]
- Ayele, A.; Haile, S.; Alemu, D.; Kamaraj, M. Comparative utilization of dead and live fungal biomass for the removal of heavy metal: A concise review. Sci. World J. 2021, 2021, 5588111. [Google Scholar] [CrossRef]
- Ahluwalia, S.S.; Goyal, D. Removal of Cr(VI) from aqueous solution by fungal biomass. Eng. Life Sci. 2010, 10, 480–485. [Google Scholar] [CrossRef]
- Loukidou, M.X.; Matis, K.A.; Zouboulis, A.I.; Liakopoulou-Kyriakidou, M. Removal of As(V) from wastewaters by chemically modified fungal biomass. Water Res. 2003, 37, 4544–4552. [Google Scholar] [CrossRef] [PubMed]
- Espinoza-Sánchez, M.A.; Arévalo-Niño, K.; Quintero-Zapata, I.; Castro-González, I.; Almaguer-Cantú, V. Cr(VI) Adsorption from aqueous solution by fungal bioremediation based using Rhizopus sp. J. Environ. Manag. 2019, 251, 109595. [Google Scholar] [CrossRef] [PubMed]
- Subbaiah, M.V.; Kalyani, S.; Reddy, G.S.; Boddu, V.M.; Krishnaiah, A. Biosorption of Cr(VI) from aqueous solutions using Trametes versicolor polyporus Fungi. J. Chem. 2008, 5, 499–510. [Google Scholar] [CrossRef]
- Samuel, S.M.; Abigail, M.E.A.; Chidambaram, R. Isotherm modelling, kinetic study and optimization of batch parameters using response surface methodology for effective removal of Cr(VI) using fungal biomass. PLoS ONE 2015, 10, e0116884. [Google Scholar] [CrossRef] [PubMed]
- Miretzky, P.; Cirelli, A.F. Cr(VI) and Cr(III) Removal from aqueous solution by raw and modified lignocellulosic materials: A review. J. Hazard. Mater. 2010, 180, 1–19. [Google Scholar] [CrossRef]
- Aigbe, U.O.; Osibote, O.A. A review of hexavalent chromium removal from aqueous solutions by sorption technique using nanomaterials. J. Environ. Chem. Eng. 2020, 8, 104503. [Google Scholar] [CrossRef]
- Garza-González, M.T.; Ramírez-Vázquez, J.E.; García-Hernández, M.D.L.Á.; Cantú-Cárdenas, M.E.; Liñan-Montes, A.; Villarreal-Chiu, J.F. Reduction of chromium (VI) from aqueous solution by biomass of Cladosporium cladosporioides. Water Sci. Technol. 2017, 76, 2494–2502. [Google Scholar] [CrossRef]
- Ren, B.; Zhang, Q.; Zhang, X.; Zhao, L.; Li, H. Biosorption of Cr(VI) from aqueous solution using dormant spores of Aspergillus niger. RSC Adv. 2018, 8, 38157–38165. [Google Scholar] [CrossRef]
- Arica, M.Y.; Bayramoǧlu, G. Cr(VI) Biosorption from aqueous solutions using free and immobilized biomass of Lentinus sajor-caju: Preparation and kinetic characterization. Colloids Surfaces A Physicochem. Eng. Asp. 2005, 253, 203–211. [Google Scholar] [CrossRef]
- Serrano-Gómez, J.; Olguín, M.T. Separation of Cr(VI) from aqueous solutions by adsorption on the microfungus Ustilago maydis. Int. J. Environ. Sci. Technol. 2015, 12, 2559–2566. [Google Scholar] [CrossRef][Green Version]
- Tewari, N.; Vasudevan, P.; Guha, B.K. Study on biosorption of Cr(VI) by Mucor hiemalis. Biochem. Eng. J. 2005, 23, 185–192. [Google Scholar] [CrossRef]
- Pourkarim, S.; Ostovar, F.; Mahdavianpour, M.; Moslemzadeh, M. Adsorption of chromium(VI) from aqueous solution by artist’s bracket fungi. Sep. Sci. Technol. 2017, 52, 1733–1741. [Google Scholar] [CrossRef]
- Thaira, H.; Raval, K.; Manirethan, V.; Balakrishnan, R.M. Melanin nano-pigments for heavy metal remediation from water. Sep. Sci. Technol. 2019, 54, 265–274. [Google Scholar] [CrossRef]
- Gadd, G.M.; de Rome, L. Biosorption of copper by fungal melanin. Appl. Microbiol. Biotechnol. 1988, 29, 610–617. [Google Scholar] [CrossRef]
- Caesar-Tonthat, T.C.; Van Ommen, F.; Geesey, G.G.; Henson, J.M. Melanin production by a filamentous soil fungus in response to copper and localization of copper sulfide by sulfide-silver staining. Appl. Environ. Microbiol. 1995, 61, 1968–1975. [Google Scholar] [CrossRef]
- Zhan, F.; He, Y.; Yang, Y.; Li, Y.; Li, T.; Zhao, Z. Effects of tricyclazole on cadmium tolerance and accumulation characteristics of a dark septate endophyte (DSE), Exophiala pisciphila. Bull. Environ. Contam. Toxicol. 2016, 96, 235–241. [Google Scholar] [CrossRef]
- Potisek, M.; Likar, M.; Vogel-Mikuš, K.; Arčon, I.; Grdadolnik, J.; Regvar, M. 1,8-Dihydroxy naphthalene (DHN)-melanin confers tolerance to cadmium in isolates of melanised dark septate endophytes. Ecotoxicol. Environ. Saf. 2021, 222, 112493. [Google Scholar] [CrossRef]
Disclaimer/Publisher’s Note: The statements, opinions and data contained in all publications are solely those of the individual author(s) and contributor(s) and not of MDPI and/or the editor(s). MDPI and/or the editor(s) disclaim responsibility for any injury to people or property resulting from any ideas, methods, instructions or products referred to in the content. |
© 2024 by the authors. Licensee MDPI, Basel, Switzerland. This article is an open access article distributed under the terms and conditions of the Creative Commons Attribution (CC BY) license (https://creativecommons.org/licenses/by/4.0/).